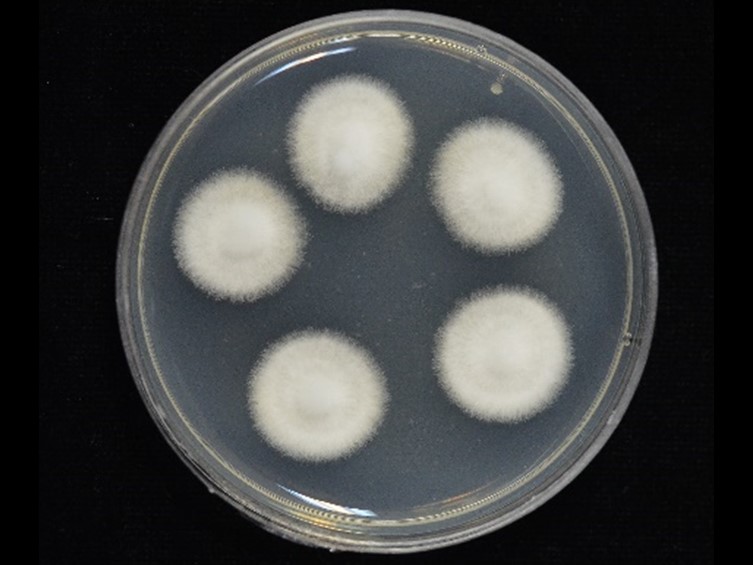

Habitat:
Underside of leaves.
Host:
Lafhoppers, Ophiocordyceps flavida.
Description:
Occurring with Ophiocordyceps flavida on Tartessus ferrugineus (Hemiptera, Cicadellidae) on the underside of Citrus maxima leaf (pomelo).  Mycelium becoming cream to white due to presence of white powdery
Mycelium becoming cream to white due to presence of white powdery  conidia, mononematous. Conidiophores arising from the mycelium covering and surrounding the host, up to 180 μm in length, 3-5 μm wide, septate, rough, terminating in a small vesicle, globose, 4-5 μm diam. Conidial heads radiating, biseriate, 40-60 μm diam. Conidiogenous branches swollen, globose, 3-5 μm diam. Conidiogenous cells flask-shaped to cylindrical, with conspicuous rachises at the upper part, 4-8 × 1.5-2 μm. Conidia hyaline, smooth, cylindrical, or narrowly obovoid, 2-6 × 1-2 μm.
conidia, mononematous. Conidiophores arising from the mycelium covering and surrounding the host, up to 180 μm in length, 3-5 μm wide, septate, rough, terminating in a small vesicle, globose, 4-5 μm diam. Conidial heads radiating, biseriate, 40-60 μm diam. Conidiogenous branches swollen, globose, 3-5 μm diam. Conidiogenous cells flask-shaped to cylindrical, with conspicuous rachises at the upper part, 4-8 × 1.5-2 μm. Conidia hyaline, smooth, cylindrical, or narrowly obovoid, 2-6 × 1-2 μm.
Culture characteristics:
Colonies on PDA attaining a diam of 10 mm in 21 d, cottony with high mycelial density, white. Mycelium smooth-walled, hyaline, sporulating poorly. Conidiogenous cells arising from aerial hyphae, solitary ovoid with conspicuous rachises at the upper part of conidiogenous cells, 4–8 × 2–5 μm. Conidia hyaline, cylindrical, or narrowly obovoid, 3–6 × 1–2.5 μm.
Colonies on PDA attaining a diam of 10 mm in 21 d, cottony with high mycelial density, white. Mycelium smooth-walled, hyaline, sporulating poorly. Conidiogenous cells arising from aerial hyphae, solitary ovoid with conspicuous rachises at the upper part of conidiogenous cells, 4–8 × 2–5 μm. Conidia hyaline, cylindrical, or narrowly obovoid, 3–6 × 1–2.5 μm.
Reference:
Mongkolsamrit S, Noisripoom W, Pumiputikul S, et al. (2021). Ophiocordyceps flavida sp. nov. (Ophiocordycipitaceae), a new species from Thailand associated with Pseudogibellula formicarum (Cordycipitaceae), and their bioactive secondary metabolites. Mycological Progress 20: 477–492.
DOI: https://doi.org/10.1007/s11557-021-01683-ySpecies |
Strain |
Compound |
Pubchem CID |
Biological activity |
Reference |
|---|
|
Strain |
LSU | RPB1 | TEF1 |
|---|---|---|---|
| BCC 81493 | MT512652 | MT533472 | MT863566 |
| BCC 84257 | MT512653 | MT533473 | MT533480 |
| CBS 433.73 | MH8724429 | MT533475 | MT533481 |
| CBS 871.72 | MH8782959 | MT533474 | MT863565 |